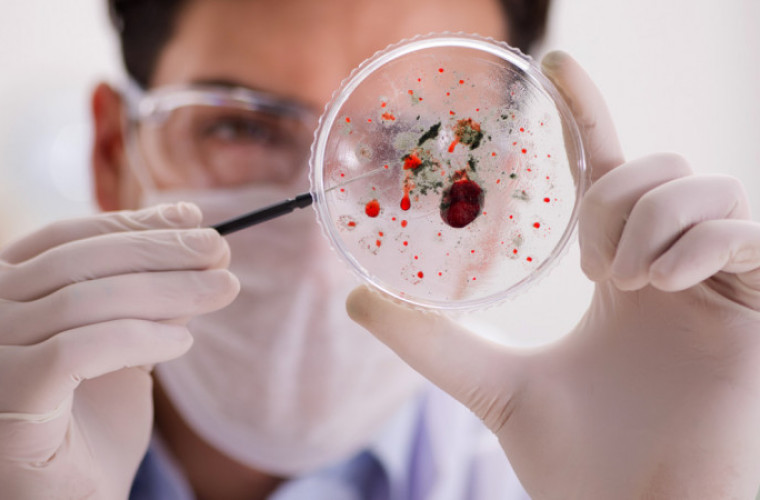

Nowe przypadki koronawirusa według województw:
śląskie (181),
mazowieckie (148),
małopolskie (136),
pomorskie (61),
wielkopolskie (54),
lubelskie (46),
podkarpackie (46),
łódzkie (39),
dolnośląskie (23),
podlaskie (17),
opolskie (15),
kujawsko-pomorskie (14),
świętokrzyskie (12),
warmińsko-mazurskie (11),
zachodniopomorskie (6),
lubuskie (2).
Jednak – według informacji przekazanych przez Wielkopolski Urząd Wojewódzki w Poznaniu - w Wielkopolsce stwierdzono nie 54, a 55 nowych przypadków zachorowania na koronawirusa. Na szczęście nie ma wśród nich mieszkańców powiatu krotoszyńskiego.


Niestety, Ministerstwo Zdrowia poinformowało także o 14 kolejnych ofiarach koronawirusa.
Tym samym w całym kraju do tej pory stwierdzono 54.487 przypadków COVID-19, z czego 1.844 osoby zmarły.
W Wielkopolsce do tej pory odnotowano 4.588 przypadków zakażenia koronawirusem, z czego 210 osób zmarło.
Jednak - mimo utrzymującej się cały czas wysokiej liczby nowych zakażeń - rząd podjął decyzję, że 1 września dzieci wrócą do szkoły. Są jednak pewne warunki. Jakie? Sprawdź!